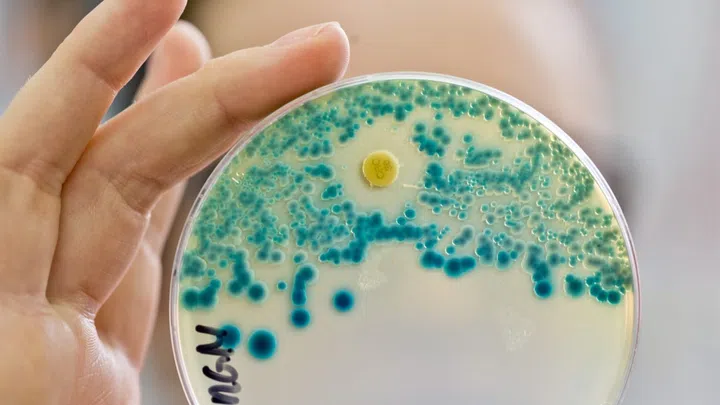

Spitäler kämpfen gegen multiresistente Keime
Antibiotika können Leben retten. Aber immer häufiger treten multiresistente Bakterien auf, die sich mit herkömmlichen Antibiotika kaum oder gar nicht mehr behandeln lassen. Wie gehen Spitäler damit um?
Abonnieren
Um diesen Podcast zu abonnieren, benötigen Sie eine Podcast-kompatible Software oder App. Wenn Ihre App in der obigen Liste nicht aufgeführt ist, können Sie einfach die Feed-URL in Ihre Podcast-App oder Software kopieren.
Teilen